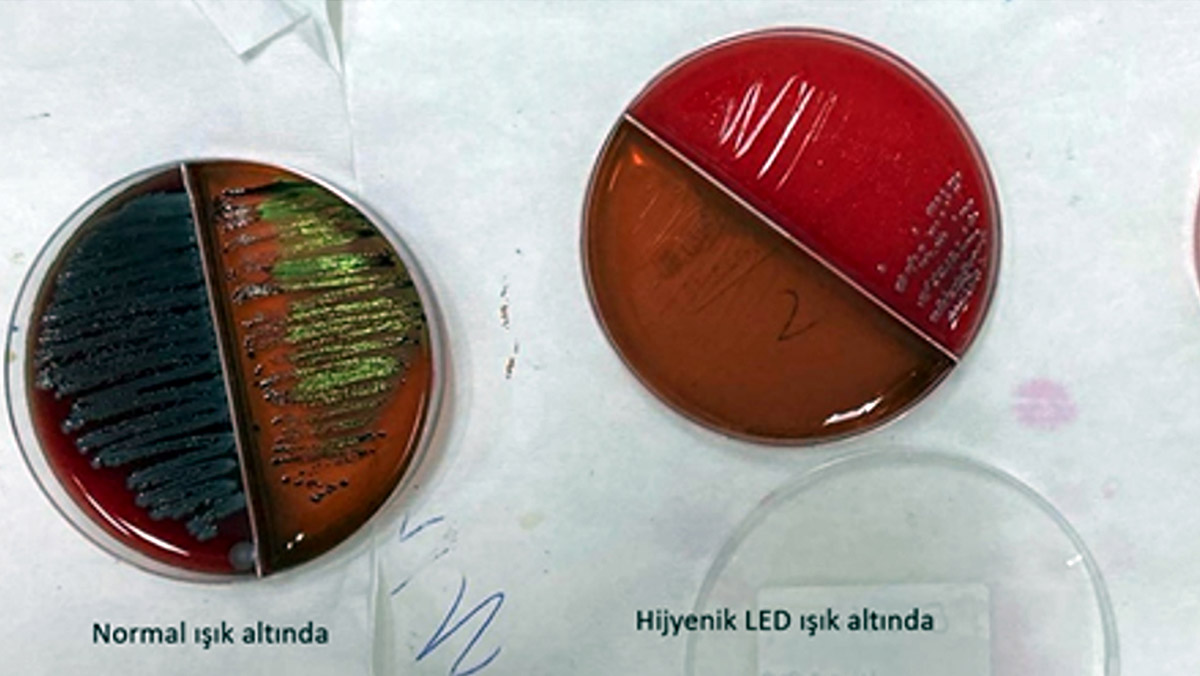

Karadeniz Teknik Üniversitesi (KTÜ) Tıp Fakültesi’nden Prof. Dr. Gürdal Yılmaz, “3 aylık araştırmamız oldu. Bu ışıkla birlikte hastane enfeksiyonlarının 3’te 1 oranında azaldığını gördük” dedi.
Bulaşıcı Hastalıkları Önleme Derneği (BUHASDER) tarafından uluslararası katılımla Antalya’nın Serik ilçesi Belek turizm merkezinde 10. BUHASDER Kongresi düzenlendi. KTÜ Tıp Fakültesi Enfeksiyon Hastalıkları Anabilim Dalı öğretim üyesi Prof. Dr. Gürdal Yılmaz, kongrede enfeksiyon hastalıkları düzeyinde ülkenin nerede olduğunu, ne yapılabileceği ve tedavi yöntemlerinden bahsettiklerini söyledi.
Prof. Dr. Yılmaz, “Dünyada her 10 yılda büyük salgınlar olmaktadır. 2010’da domuz gribi, 2020’de Covid-19 gibi. Bunların yanında hastane enfeksiyonları da olmaktadır. Son dönemlerde antibiyotik gelişiminin azalması ile birlikte antibiyotik dirençli mikroorganizmalarla karşı karşıya kalabiliyoruz.

Burada önemli olan enfeksiyon gelişmeden tedavi edebilmek. Enfeksiyon geliştiğinde ya ilaç olmayabiliyor ya da ilaç kullanılacak kişilerde ilaçların oluşturduğu yan etkilerle mücadele etmek zorunda kalıyoruz” dedi.
Hastane enfeksiyonu maliyetlerine de değinen Prof. Dr. Yılmaz, “Amerika’da bu maliyetler milyar dolarlarla telaffuz ediliyor. Ülkemizde de benzer maliyetler var. Bunun yanında hayati önem de var. Birçok hastayı bu enfeksiyonlardan kaybediyoruz. Salgından dolayı belki insanlar kurtuluyor ama yan etkilerinden dolayı bazı hastaları kaybedebiliyoruz” diye konuştu.
‘HASTANE ENFEKSİYONLARININ 3’TE 1 AZALDIĞINI GÖRDÜK’
1990’lı yıllarda başlayan ışık teknolojisinden bahseden Prof. Dr. Gürdal Yılmaz, şöyle konuştu:
“Ultraviyole ışıkla birlikte ‘ışığın teknolojisini nerelerde kullanabiliriz’ noktasında gelişmeler oldu. Mavi ışık ortaya çıktı. Son 10 yıldır gün ışığı teknolojisinin enfeksiyonla mücadelesinde ne yapılabilir, gün ışığı teknolojisinin enfeksiyonla mücadelesindeki yerini ortaya koymak için çalışmalar yaptılar ve hijyenik LED ışık kavramı gündeme geldi. Laboratuvar şartlarında LED ışığın mikroorganizmaları yüzde 80’in üzerinde düşürdüğünü gördük.
Karadeniz Teknik Üniversitesi olarak yoğun bakım ünitelerine bunları aldık. 3 aylık araştırmamız oldu. Bu ışıkla birlikte hastane enfeksiyonlarının 3’te 1 oranında azaldığını gördük. Işık hastanın üzerinde devamlı normal ışık gibi durduğunda nüfuz ettiği yerlerdeki mikroorganizmanın çoğalmasını engellediği ve öldürmesiyle birlikte mikroorganizmanın insanda hastalık yapacak kadar çoğalmamasını önleme gibi etkisi var.
Bununla birlikte bir aşama katetmiş olacağız. Başka teknolojiler ile birlikte enfeksiyonlar oluşmadan hastalığı önlemiş olacağız. Özellikle son dönemde nüfusun artması, turizmin çok olması, insanların çok seyahat etmesi nedeniyle salgınlar çok hızlı yayılmakta. Bu tür teknolojilerin sağlık sistemine girmiş olması bizi mutlu etmektedir.”












